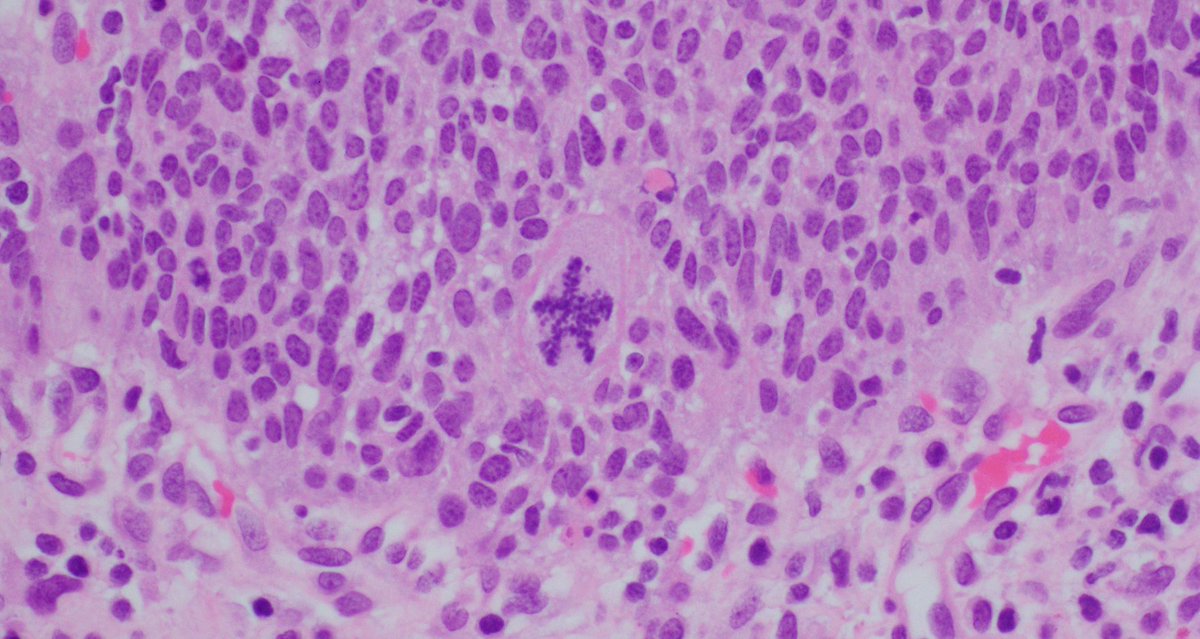

UW Dept of Pathology and Laboratory Medicine
@uwiscpathology
ID: 1283875486997807104
https://pathology.wisc.edu/ 16-07-2020 21:26:50
123 Tweet
1,1K Followers
43 Following





🤩🙌 Congratulations to Dr. Qinyuan Li (Qinyuan Li ) on winning the ASCP TRIG Genomics 101 Workshop Award 🌟 along with the ASCP Travel Award! ✨ This recognition is a testament to your passion and hard work — keep shining and inspiring others! 🎉👏










🎉Continuing our celebration of the 2025 CAPA GoPath Best Abstract Award winners(2/3)! 🥉 Yan Feng from Indiana University IUPathology 🥉 Qiong Zhang from Univ. of Wisconsin UW Dept of Pathology and Laboratory Medicine 🥉 Ping Shi from Penn State University Penn State Health